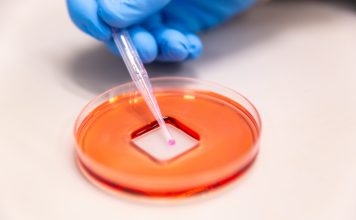

Funding boost for project that reduces emissions with the help of seaweed
Agricultural science company Sea Forest has received $1 million in matched funding to scale up production of a special seaweed additive for livestock feed...
Ansell introduces new light duty protective gloves for chemical environments
Global leader in protective solutions Ansell has introduced a new light duty glove with optimal performance and flexibility for workers exposed to irritant contact...
Pharmaxis’ locally manufactured cystic fibrosis drug lands in the US
Australian pharmaceutical research company Pharmaxis Ltd (ASX:PXS) exported the first shipment of its locally developed and manufactured cystic fibrosis (CF) drug Bronchitol™ (mannitol) to...
Manual work meets modern automation to empower workers with handicaps
Product Release - Mitsubishi Electric
In spite of advancing digitalization, the following still applies: Manual workstations are indispensable, because automation is not always profitable with...
Condari releases revolutionary Rangecraft Rangehoods on Australian market
Condari Pty Limited, the Melbourne-based manufacturers of the high-end brands Qasair and Condor Rangehoods, recently released its new brand of rangehood which utilises revolutionary...
Dassault Systèmes’ new 3D drawingless application cuts costs and boosts manufacturing process
Dassault Systèmes has launched the SOLIDWORKS Model Based Definition (MBD) – a powerful drawingless manufacturing application that improves design and manufacturing processes and reduces...
Australian made low-cost household disinfectant proven to kill COVID-19 virus now available
Virosol+, an Australian owned and manufactured low-cost household disinfectant surface spray that is proven to kill SARS-CoV-2, is now available to purchase for consumers.
Customers...
Amcor’s AmLite HeatFlex Recyclable wins prestigious industry award
Australian packaging giant Amcor was recently recognized with a Gold Innovation Award for its AmLite HeatFlex Recyclable packaging.
The award was presented on 21 March...
Fronius unveils world’s first lithium battery powered MMA welder
SMENCO — one of Australia’s leading distributors of welding equipment, consumables and associated welding technology from all over the world — has announced the...
Australian Made gifts support to Aussie manufacturers through new partnership
The Australian Made Campaign (AMCL) is partnering with Australian Gift & Homewares Association (AGHA) to support the growth of Australia's gift and homeware manufacturing...